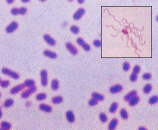
�Z���`�A�ۂ̃C���[�W

| 鞭毛が周りに生えてくる | 2本の鞭毛が印象的なフォルム |
|
 |
| 【セラチア菌】 大阪府堺市の耳原総合病院で2000年5〜6月に相次ぎ、7名が犠牲になった院内感染の原因菌。以前は“霊菌”と呼ばれ、非病原菌と考えられていたが、抵抗力の弱くなったときに感染するやっかいな菌。 又もや東京都世田谷区の「伊藤脳神経外科病院」でセラチア菌による院内感染で7名(24歳〜91歳)が死亡。(2002/01/19) |
【カンピロバクター】 ブタ、犬、鳥の腸内に分布する病原菌。肉類の加工品などから感染し、吐き気、腹痛、下痢などの症状を引き起こす。2000年も新潟県糸魚川市の高校で合宿をしていた野球部員が食中毒にかかった。 |
| 見た目は以外とカワイラシイ・・!? | 煮てもダメ・・・なんと手強いヤツ! |
 |
 |
| 【黄色ブドウ球菌】 雪印乳業の事件で、大阪工場のバルブから検出されたという菌。自身は毒性をもたないが、エンテロトキシンという毒素を作り、それが食中毒の原因になる。嘔吐や下痢が突然始まるのが特徴。 |
【ウェルシュ菌】 岩手県滝沢村の下宿でなんと22名もの学生が腹痛などの症状を訴えた原因菌がこれ。肉や魚料理から感染し、下痢や吐き気、腹痛を引き起こす。熱に強く、100℃で1〜4時間加熱しても死なないという。 |
| 大量の鞭毛が不気味な曲者 | |
 |
|
| 【セレウス菌】 これも雪印大阪工場から微量ながら検出された病原菌。本来は土壌やホコリに存在する。嘔吐型と、下痢型があり、嘔吐型はご飯やスパゲティなど、下痢型は食肉製品などと、原因となる食物も違う。 |
│TOPページ │ 関連記事(腸内細菌)へ